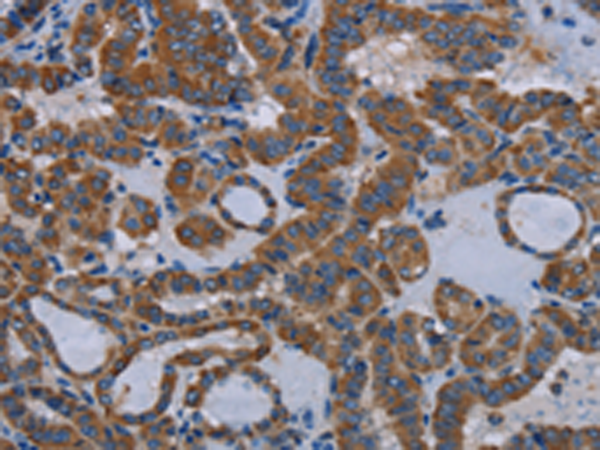
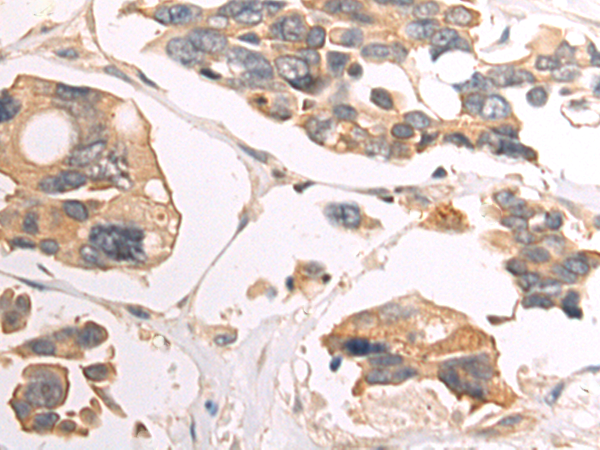

-
分类: 科研抗体货号: P10797别名: HsT17299应用: IHC反应种属: Human
-
分类: 科研抗体货号: P10808别名: DAP-3, 4921514D13Rik应用: WB,IHC反应种属: Human, Mouse
-
分类: 科研抗体货号: P10795别名: CCN1; CCNA应用: WB反应种属: Human
-
分类: 科研抗体货号: P10807别名: P97, AAG1, DAP5, NAT1应用: WB反应种属: Human, Mouse
-
分类: 科研抗体货号: P10828别名: ERBB, HER1, mENA, ERBB1, PIG61应用: WB,IHC反应种属: Human, Mouse
-
分类: 科研抗体货号: P10805别名: XPE, DDBA, XAP1, XPCE, XPE-BF, UV-DDB1应用: WB,IHC反应种属: Human, Mouse, Rat
-
分类: 科研抗体货号: P10827别名: ETB; ET-B; ETBR; ETRB; HSCR; WS4A; ABCDS; ET-BR; HSCR2应用: IHC反应种属: Human
-
分类: 科研抗体货号: P10804别名: CD205; LY-75; CLEC13B; DEC-205; GP200-MR6应用: IHC反应种属: Human
-
分类: 科研抗体货号: P10826别名: ETA; ET-A; ETAR; ETRA; MFDA; ETA-R; hET-AR应用: WB,IHC反应种属: Human, Mouse
-
分类: 科研抗体货号: P10803别名: LAMP; CD208; DCLAMP; LAMP-3; TSC403; DC LAMP; DC-LAMP应用: WB,IHC反应种属: Human

鄂公网安备42018502007531号
鄂公网安备42018502007531号

